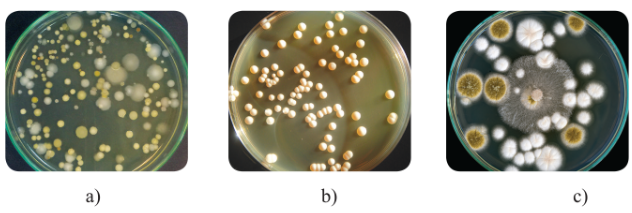
Khuẩn lạc vi sinh vật

Vi sinh vật và các phương pháp nghiên cứu vi sinh vật CD
I. Khái niệm vi sinh vật

Khái niệm: Vi sinh vật là các sinh vật có kích thước nhỏ, thường không nhìn thấy bằng mắt thường mà chỉ quan sát được bằng kính hiển vi.
Ví dụ: vi khuẩn lactic, nấm men, trùng roi, trùng giày, tảo silic,…
Vi sinh vật gồm có các nhóm: vi khuẩn và vi sinh vật cổ (giới Khởi sinh), tảo đơn bào và nguyên sinh động vật (giới Nguyên sinh), vi nấm (giới Nấm).
Đặc điểm chung của vi sinh vật:
+ Kích thước nhỏ, thường chỉ quan sát được bằng kính hiển vi.
+ Đa số có cấu tạo đơn bào nhân sơ hoặc nhân thực.
+ Số lượng nhiều và phân bố rộng.
+ Hấp thu và chuyển hóa vật chất nhanh, sinh trưởng và sinh sản nhanh. Khả năng sinh trưởng và sinh sản nhanh của vi sinh vật là một thế mạnh mà công nghệ sinh học đang tập trung khai thác.

* Nhận xét về mối liên hệ giữa kích thước và thời gian chu kì tế bào của vi sinh vật: Tốc độ trao đổi chất của tế bào sinh vật phụ thuộc vào tỉ lệ S/V (tỉ lệ giữa diện tích bề mặt và thể tích tế bào). Kích thước càng nhỏ, tỉ lệ S/V càng lớn thì tốc độ trao đổi chất càng lớn khiến cho tốc độ sinh trưởng và sinh sản của tế bào càng nhanh (chu kì tế bào càng ngắn).
II. Các kiểu dinh dưỡng ở vi sinh vật
- Dựa vào nguồn cung cấp năng lượng và nguồn carbon sử dụng, vi sinh vật có 4 kiểu dinh dưỡng là: Quang dị dưỡng, hóa dị dưỡng, quang tự dưỡng và hóa tự dưỡng.
| Nguồn carbon | Nguồn năng lượng | |
| Ánh sáng | Phản ứng hóa học | |
| Hữu cơ |
Quang dị dưỡng Vi khuẩn không chứa lưu huỳnh màu lục và màu tía. |
Hóa dị dưỡng Vi nấm, nguyên sinh động vật, đa số vi khuẩn |
| CO2 |
Quang tự dưỡng Vi khuẩn lam, vi tảo, vi khuẩn lưu huỳnh màu tía và màu lục. |
Hóa tự dưỡng Vi khuẩn oxi hóa hydrogen, lưu huỳnh, sắt hoặc nitrate hóa. |
- Các nhà khoa học đã tạo ra môi trường chứa các chất dinh dưỡng phù hợp để nuôi vi sinh vật. Ví dụ: Để nuôi nấm mốc thì thường sử dụng môi trường Czapek – Dox, gồm các thành phần: 30 g sucrose; 2 g NaNO3; 1 g K2HPO4; 0,5 g MgSO4; 0,5 g KCl; 0,01 g FeSO4; 1 lít nước.
III. Một số phương pháp nghiên cứu vi sinh vật
- Một số phương pháp nghiên cứu vi sinh vật: phân lập, nuôi cấy và giữ giống, quan sát hình thái, nghiên cứu đặc điểm hóa sinh, sinh lí, di truyền,…
- Mục đích của các phương pháp nghiên cứu: giúp người nghiên cứu hiểu rõ hơn về các đặc điểm của vi sinh vật nhằm khai thác, ứng dụng vi sinh vật trong đời sống.
1. Phân lập vi sinh vật
- Phương pháp phân lập nhằm tách riêng từng loài vi sinh vật từ hỗn hợp nhiều loài vi sinh vật bằng cách pha loãng và trải đều mẫu trên môi trường đặc.
- Tế bào từng loài vi sinh vật phát triển trên bề mặt môi trường đặc sẽ tạo ra những khuẩn lạc có hình thái đặc trưng nên có thể dựa vào đó để phân biệt và tách riêng từng khuẩn lạc vi sinh vật cần nghiên cứu:
+ Khuẩn lạc vi khuẩn thường nhầy ướt, bề mặt thường dẹt và có nhiều màu sắc (trắng sữa, vàng, đỏ, hồng, cam,…), một số khuẩn lạc đặc biệt có dạng bột mịn.
+ Khuẩn lạc nấm men thường khô, tròn đều và lồi ở tâm, khuẩn lạc thường có màu trắng sữa.
+ Khuẩn lạc nấm mốc thường lan rộng do tế bào nấm mốc phát triển tạo thành dạng sợi dài, xốp, khuẩn lạc có nhiều màu sắc khác nhau như trắng, vàng, đen, xanh,…
2. Nghiên cứu hình thái vi sinh vật
- Phương pháp nghiên cứu hình thái thường được sử dụng để nhận biết nhóm vi sinh vật.
- Quy trình nghiên cứu hình thái vi sinh vật:
+ Phương pháp quan sát gồm hai bước là chuẩn bị mẫu và quan sát bằng kính hiển vi.
+ Tùy từng đối tượng vi sinh vật mà quy trình thực hiện nghiên cứu hình thái có thể có những điểm khác nhau nhất định. Ví dụ: Mẫu vi khuẩn và nấm men thường sẽ làm vết bôi, nhuộm với xanh methylene hoặc fuchsin sau đó quan sát bằng kính hiển vi ở vật kính 100×, nấm mốc và nguyên sinh vật có thể quan sát trực tiếp bằng kính hiển vi ở vật kính 10× hoặc 40×.

3. Nghiên cứu đặc điểm hóa sinh của vi sinh vật
- Các hợp chất tham gia cấu tạo và thực hiện các chức năng sống của tế bào vi sinh vật có thể được nhận biết thông qua một số phản ứng hóa học.
- Quy trình nghiên cứu đặc điểm hóa sinh của vi sinh vật gồm 2 bước: chuẩn bị mẫu và thực hiện phản ứng hóa học để nhận biết các chất có ở vi sinh vật.
+ Ví dụ: Nhận biết sự có mặt của enzyme catalase trong hai mẫu vi khuẩn: mẫu vi khuẩn có catalase sẽ phản ứng với nước oxi già (H2O2) để tạo ra nước và oxygen, ngược lại, vi khuẩn không có catalase sẽ không phản ứng với nước oxi già.

IV. Thực hành một số phương pháp nghiên cứu vi sinh vật
1. Phân lập các vi sinh vật trong không khí
1.1. Chuẩn bị
- Dụng cụ: 9 đĩa petri (đường kính 10 cm) vô trùng, đũa thủy tinh, băng dính, găng tay, khẩu trang, bếp điện hoặc bếp từ, nồi có nắp (đường kính khoảng 20 cm), rổ lỗ nhỏ, cốc đong (thể tích 1 lít).
- Nguyên liệu: 100 g thịt bò thái nhỏ (2 – 3 cm), 300 mL nước, 4 g thạch.
1.2. Tiến hành
- Bước 1: Cho thịt bò, nước vào nồi và đun sôi trong khoảng 5 phút.
- Bước 2: Sử dụng rổ và cốc đong để lọc lấy nước thịt bò.
- Bước 3: Cho 4 g thạch vào nước thịt bò, dùng đũa thủy tinh khuấy đều và đun sôi trong khoảng 3 phút tạo thành môi trường nước thịt bò.
- Bước 4: Đậy nắp nồi và chờ 3 – 5 phút cho nhiệt độ môi trường nước thịt bò giảm xuống còn khoảng 60 – 80 oC.
- Bước 5: Lấy 9 đĩa petri và đổ vào mỗi đĩa khoảng 25 mL môi trường nước thịt bò.
- Bước 6: Mở nắp đĩa petri và để trong không khí ở các thời gian khác nhau: 5, 10 và 15 phút tương ứng với 3 lô thí nghiệm (mỗi lô có 3 đĩa).
- Bước 7: Đánh dấu và đậy nắp đĩa petri, sau đó dùng băng dính quấn xung quanh và giữ chặt nắp.
- Bước 8: Giữ đĩa petri ở nhiệt độ khoảng 30 – 35 oC trong khoảng 2 – 3 ngày.
- Bước 9: Quan sát các lô thí nghiệm và ghi thông tin theo gợi ý như bảng dưới đây:
| Thời gian | Số lượng khuẩn lạc | Màu sắc khuẩn lạc | Hình dạng khuẩn lạc |
| 5 phút | ? | ? | ? |
| 10 phút | ? | ? | ? |
| 15 phút | ? | ? | ? |
1.3. Báo cáo
- Viết báo cáo theo gợi ý ở bài 6.
- Thảo luận trả lời các câu hỏi sau:
+ Tại sao lại mở nắp đĩa petri và để trong không khí 5, 10 và 15 phút? So sánh kết quả ở các lô khác nhau.
+ Tại sao lại phải dùng băng dính quấn chặt miệng đĩa petri?
+ Em hãy tìm hiểu thông tin và nêu cách nhận biết khuẩn lạc vi khuẩn, nấm mốc và nấm men. Đồng thời, hãy đánh dấu từng loại khuẩn lạc đó (nếu có) trong mẫu phân lập.
2. Quan sát hình thái nấm mốc, vi khuẩn và nấm men
2.1. Chuẩn bị
- Mẫu vật: mẩu bánh mì, vỏ quả chín hoặc hạt bị mốc; nước dưa chua; bánh men rượu hòa trong nước.
- Hóa chất: thuốc nhuộm xanh methylene hoặc fuchsin.
- Dụng cụ: lam kính, que cấy, bình tia nước, giấy thấm, đèn cồn, chậu rửa, kính hiển vi, dầu soi kính, panh.
2.2. Tiến hành
Quan sát nấm mốc
- Bước 1: Dùng panh gắp mẫu vật (mẩu bánh mì, vỏ quả hoặc hạt bị mốc) cho lên lam kính.
- Bước 2: Đặt lam kính lên bàn kính và quan sát ở vật kính 10×.
Lưu ý: tập trung quan sát hệ sợi và cơ quan sinh sản của nấm mốc, có thể chuyển sang vật kính 40× để quan sát rõ hơn.
Quan sát vi khuẩn hoặc nấm men
- Bước 1: Dùng que cấy lấy mẫu vật (nước dưa chua hoặc dịch bánh men) cho lên lam kính và dàn đều.
- Bước 2: Hong khô tiêu bản trên ngọn lửa đèn cồn.
- Bước 3: Nhỏ 1 giọt thuốc nhuộm lên trên tiêu bản và giữ trong 1 phút.
- Bước 4: Rửa thuốc nhuộm bằng bình tia nước.
- Bước 5: Thấm khô tiêu bản, đặt lên bàn kính và quan sát ở vật kính 10× để chọn tiêu cự phù hợp rồi chuyển sang vật kính 100× (vật kính dầu) để quan sát.
- Bước 6: Vẽ lại hình ảnh quan sát được dưới kính hiển vi vào vở.
2.3. Báo cáo
- Viết báo cáo theo gợi ý ở bài 6.
- Thảo luận để trả lời các câu hỏi:
+ Em có nhận xét gì về đặc điểm hình dạng, kích thước của nấm mốc, nấm men và vi khuẩn?
+ Nêu hình thức sinh sản của vi khuẩn, nấm mốc và nấm men trong các mẫu quan sát.
3. Xác định khả năng sinh catalase
3.1. Chuẩn bị
- Mẫu vật: vi khuẩn, nấm men phân lập được trên môi trường nước thịt, chế phẩm men tiêu hóa (vi khuẩn) dạng bột.
- Dụng cụ: lam kính, que cấy.
- Hóa chất: dung dịch nước oxi già.
3.2. Tiến hành
- Bước 1: Dùng que cấy lấy mẫu tế bào vi khuẩn hoặc nấm men hoặc chế phẩm men tiêu hóa cho lên lam kính.
- Bước 2: Nhỏ 1 giọt dung dịch nước oxi già lên mẫu vật.
- Bước 3: Thu thập số liệu.
Quan sát hiện tượng xảy ra và ghi lại thông tin theo gợi ý như bảng:
| Mẫu vi khuẩn | Mẫu nấm men | Mẫu vi khuẩn trong men tiêu hóa | |
| Tạo bọt khí | ? | ? | ? |
3.3. Báo cáo
- Viết báo cáo theo gợi ý ở bài 6.
- Thảo luận để trả lời các câu hỏi sau đây:
+ Trình bày cơ chế hình thành bọt khí.
+ Nước oxi già có chứa khoảng 3 % H2O2 thường được dùng để khử trùng vết thương. Em hãy nêu cơ sở khoa học của ứng dụng này.







